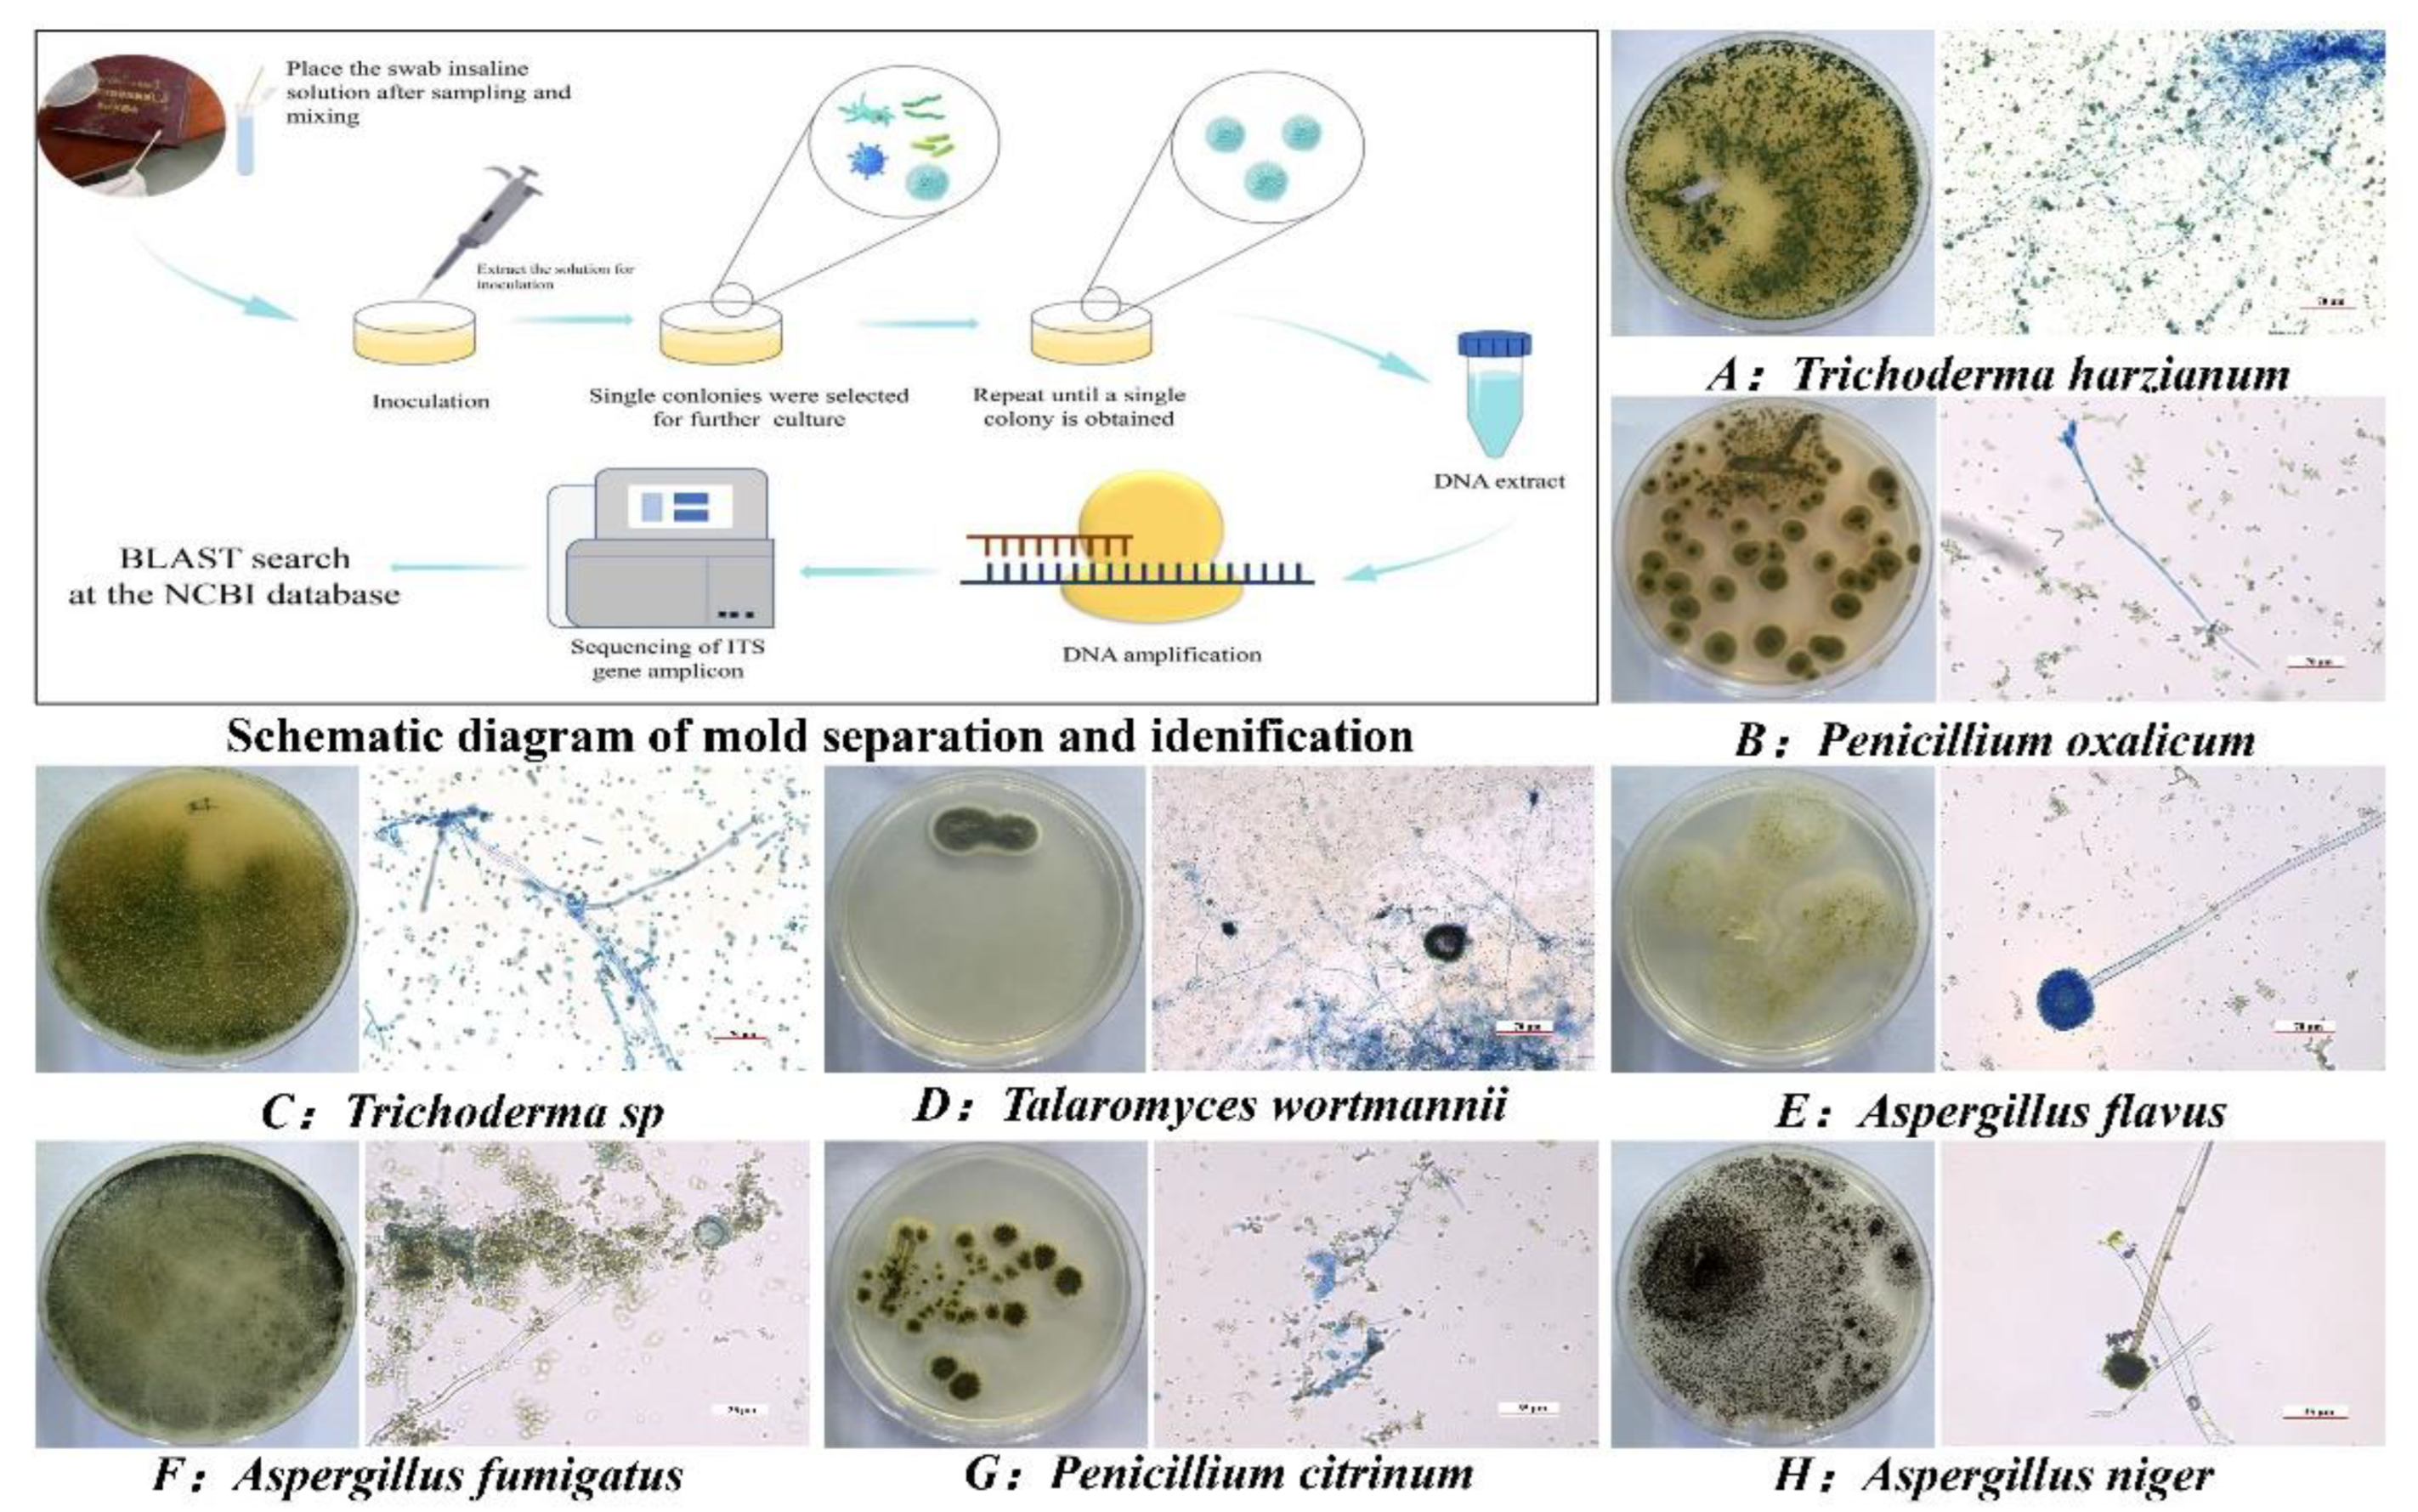
Coatings 13 00745 g003

Abstract
Archives, ancient books, and documents kept in museums and libraries are the carriers of historic and cultural information left by our ancestors. However, these paper cultural relics can show notorious signs of degradation, e.g., fungal development. Due to the organic components of paper objects, they suffer from fungal biodeterioration. The excreted substances of fungi and the fungi’s structures themselves are often colored and interfere with the readability of the artifacts, diminishing their artistic and monetary values. In this study, we collected and separated the moldy archives collected in the Archives of Shaanxi Province (China) and obtained the identification results of eight kinds of molds. Clotrimazole (CTZ) and quaternary ammonium salt chitosan (HACC) were combined to prepare a microemulsion. Synergies of CTZ and HACC could enhance the antifungal effect and reduce the required concentration of a single drug. The composite emulsion could effectively improve the retention of drugs on the surface of paper cultural relics, improve the solubility of hydrophobic drugs, and provide a data basis for the anti-mold preservation of paper cultural relics.
1. Introduction
Ancient books, archives, and documents of culture have important historical, artistic, and scientific values [1,2]. However, in the long process of preservation, paper-based cultural relics can be affected by various factors, such as physical, chemical, and biological factors [3]. These paper cultural relics exhibit varying degrees of degradation, as the cellulose and other components contained in paper-based cultural relics are conducive to the growth of fungi [4,5,6,7,8]. Pigments or organic acids produced by some mitotic fungi that can degrade paper fibers can cause serious damage to paper cultural relics [9].
In recent years, it was discovered that as a broad-spectrum antifungal agent, the poor water solubility of clotrimazole (CTZ) limits its effective antifungal treatment [10,11,12]. Chitosan quaternary ammonium salt (HACC), as a derivative of chitosan, exhibits better water solubility and strong antibacterial activity [13,14,15]. It has been widely applied in fields of medicine and health [16,17], wastewater treatment [18], etc.
Microemulsions, with droplet sizes in the range of 10–100 nm, are thermodynamically stable solubility products consisting of an oil phase, aqueous phase, a surfactant, and a co-surfactant [19,20]. Solubility of CTZ is improved by formulating it in a microemulsion drug delivery system [21]. The study of Bożena Grimling et al. demonstrated that chitosan acts synergistically with CTZ against non-albicans candida strains [22]. However, limited research can be found on the preparation of microemulsions with clotrimazole and quaternary ammonium chitosan for the conservation of paper cultural relics against mold. In this study, CTZ, which is insoluble in water, and HACC, which is insoluble in oil, are mixed to prepare a microemulsion to verify the synergistic effect of CTZ and HACC on the antifungal effect (Figure 1). By referring to the literature [23], clove oil, water, and Tween-20 were used as solvents to prepare the microemulsion with CTZ and HACC in order to provide data evidence for mold control for paper cultural relics.

Figure 1.
Schematic illustration of the antifungal effect of microemulsion formulations.
2. Material Identification and Experimental Methods
2.1. Materials
Potato dextrose agar (PDA) medium, purchased from Aobox Biotechnology (Beijing, China), was used for mold isolation and the inhibition experiment. Clove oil, clotrimazole (CTZ), chitosan quaternary ammonium salt (HACC), lactic acid phenol cotton blue stain, and Tween-20 were purchased from Shanghai Macklin Biochemical Technology Co., Ltd. (Shanghai, China), Shanghai Yuanye Bio-Technology Co., Ltd. (Shanghai, China), Beijing Leagene Biotech (Bejing, China), and Shanghai Shanpu Chemical Co., Ltd. (Shanghai, China). Penicillium citrinum, Aspergillus flavus, Aspergillus niger, Penicillium oxalicum, Penicillum citeonigrum, Trichoderma sp., Aspergillus fumigatus, and Trichoderma harzianum were isolated from moldy papers and storage environments in the Shaanxi Provincial Archives (Shaanxi, China).
2.2. Isolation and Identification of Mold
The sterile cotton swab was dipped in sterile physiological saline to sample mold from the archives and then lined on potato glucose agar (PDA) medium, which was incubated for 48 h at 28 °C. The pure colonies were obtained using a sterile loop to scoop the single colonies to the sub-culture in a PDA medium. Then, the images of the pure colonies were captured. The small amount of mycelium was selected with an inoculation ring and dyed with lactic acid phenol cotton blue dye; then, the photographs of the mycelia and spores were obtained with a microscope. The identification of mold was acquired with the morphology of fungi [24,25,26,27,28,29,30] and molecular biology techniques.
Genomic DNA was extracted from the isolates using a DNeasy Plant Mini Kit (Qiagen, Valencia, CA, USA). The DNA was used as a template for ITS-PCR, with the primer pair ITS1 (5′-TCCGTAGGTGAACCTGCGG-3′) and ITS4 (5′-TCCTCCGCTTATTGATATGC-3′). PCRs were performed in 25 μL of reaction mixtures, with 0.2 μM of each primer, 5 μL of DNA template, and reagents from a QIAGEN TopTaq PCR Master Mix kit. The cycling profile was as follows: initial denaturation at 94 °C for 4 min, followed by 35 cycles of denaturation at 94 °C for 45 s, annealing at 54 °C for 1 min, extension at 72 °C for 1 min, and a final extension step at 72 °C for 10 min. Reaction products were separated on 1% agarose gel, and bands were stained with ethidium bromide and visualized under UV transillumination. PCR products were purified with a EzWay PCR Clean-up purification kit (Sangon Biotech, Shanghai, China). The purified PCR products were sequenced using ITS1 and ITS4 primers at Sangon Biotech Co., Ltd. (Shanghai, China). The generated sequences were matched by nBLAST to library sequences in the GenBank database.
2.3. Microemulsion Formulations
2.3.1. The Effect of Mixed CTZ and HACC
In order to verify the inhibitory effect of mixed CTZ and HACC on mold, we prepared three sets of microemulsions numbered 1, 2, and 3, respectively (Table 1). CTZ, HACC, clove oil, Tween-20, and water were properly mixed with a vortex meter. These microemulsions were kept in ultrasound for 10 min to obtain a transparent microemulsion for the subsequent bacteriostasis test.

Table 1.
Three sets of microemulsion compositions.
2.3.2. Synergistic Role
In order to verify that the combination of CTZ and HACC plays a synergistic role in the inhibition of mold, the concentration parameters were optimized, as presented in Table 2, and named C, H, and CH, respectively. CTZ, HACC, clove oil, Tween-20, and water were mixed properly with the help of a vortexer. These microemulsions were kept in a sonication bath for 10 min until they became transparent (Figure 2). The microemulsions were then allowed to stand for 24 h at room temperature to observe color changes, signs of turbidity, or phase separations [31].

Table 2.
Three sets of microemulsion compositions.

Figure 2.
Three sets of microemulsions after optimization. Labels 1, 2, and 3 represent C, H, and CH, respectively.
2.4. Characterization of CH Microemulsion
2.4.1. The Type of CH Microemulsion
The type of microemulsion was determined using the staining method. Sudan dye Ⅲ (oil-soluble) and methylene blue (water-soluble) were dropped into two sample bottles with 10 mL of CH microemulsions in order to observe diffusion rates and color changes in the stained CH microemulsions. If the Sudan dye III in the microemulsion spread faster than the one dyed with methylene blue, it was determined as water-in-oil (W/O); on the contrary, if the Sudan dye III in the microemulsion spread slower than the one dyed with methylene blue, it was determined as oil-in-water (O/W).
2.4.2. Particle Size and Polydispersity Index (PDI) Analysis
The average particle size and PDI of the emulsion droplets were determined by photon correlation spectroscopy (Nano ZS90, Malvern Instruments, Worcestershire, UK), which is based on the principle of dynamic light scattering (DLS). In DLS, the sample is illuminated with a laser beam, and the intensity of the resulting scattered light produced by the particles fluctuates at a rate that is dependent upon the sizes of the particles. An analysis of these intensity fluctuations yields the diffusion coefficient of the particles and hence the particle size. All measurements were carried out at 25 °C [32].
2.4.3. Determination of Zeta Potential
Emulsion formulation (0.1 mL) was diluted 100 times using double-distilled water and analyzed. Zeta potential was determined using a zeta potential measuring instrument (Nano ZS90, Malvern Instruments, Worcestershire, UK). All measurements were carried out at 25 °C [32].
2.4.4. TEM Analysis
Transmission electron microscopic (TEM) analysis was performed to determine the shape of the dispersed phase. A drop of diluted emulsion was applied to a copper grid and left for 1 min. Then, the grid was kept inverted, and a drop of phosphotungstic acid (PTA) was applied to the grid for 1 min, and the grid was analyzed using the TEM (JEM-2800, JEOL Ltd., Tokyo, Japan) operated at 200 kV [31].
2.5. Anti-Fungal Experiment
Penicillium citrinum, Aspergillus flavus, Aspergillus niger, Penicillium oxalicum, Penicillium citrinum, Trichoderma sp., Aspergillus fumigatus, and Trichoderma harzianum were placed in an inclined tube in a 25 °C incubator and grown on PDA. Then, 0.05% Tween 20 was used to separate fungal spores, and the result was filtered through gauze. After counting mold spores with a blood cell counting plate, spore suspension was diluted with phosphate-buffered saline (PBS) until a 1 × 105 colony-forming unit (CFU) was obtained. A total of 100 μL of a 1 × 105 CFU/mL spore suspension was coated on PDA medium, and the medium was evenly divided into four parts along the center. The mold resistances of the three microemulsions were tested using an Oxford cup.
An Oxford cup was placed in the center of each part, and 100 μL of normal saline solution was added to the control group, while 100 µL of microemulsion was added to the treatment group. After incubating these plates at 25 °C for 48 h, the size of the mold inhibition zone was observed, and images were collected. The combined concentrations of clotrimazole and quaternary ammonium salt chitosan were screened to verify their synergistic effect. An amount of 1 × 105 CFU/mL spore suspension and 100 uL of microemulsion were added to the 24-hole plate, and each treatment group was repeated three times. After the 24-hole plate was placed at room temperature for 6 h, it was blown evenly with a pipette, and 100 uL of liquid was coated on the PDA medium. After cultivating these plates at 25 °C for 48 h, the number of colonies was observed and quantified.
2.6. Mechanical Property Test of Paper after Treatment
The printing paper, xuan paper, and manuscript paper were cut into 1.5 × 15 cm paper strips, in which xuan paper was cut horizontally and vertically and marked as xuan paper H and xuan paper Z. Four kinds of paper samples were sprayed with synergistic microemulsion (CH). After they were completely dried, the qt-1136pc universal material testing machine (Dongguan Gaotai Testing Instrument Co., Ltd., Dongguan, China) and the lbmit135 origami tester (Shenzhen Lanbo Testing Instrument Co., Ltd, Labo, Shengzhen, China) were used to test the tensile strengths and folding resistances of the four kinds of paper samples before and after treatment [33,34,35].
2.7. Determination of Optical Properties
Colorimetric measurements were carried out to determine L*, a*, and b* coordinate color space values for the untreated paper and those coated with the CH microemulsion (Table 2) using the X-Rite VS450 spectrophotometer (Aiselei (Shanghai) Color Technology Co., Ltd, Shanghai, China). Triplicate measurements were performed for each sample [36], and the color differences (ΔE) were determined before and after treatment. The CIE whiteness index was determined according to the standard GB/T 22880-2008 [37].
2.8. Determination of pH
Surface pH measurements were executed using pH meter Jenway 3510 (Cole-Parmer Ltd., Shanghai, China), using the flat-surface-combined pH electrode. A drop of water with a volume of 50 µL was placed on a sample; the pH electrode was pressed against it, and the pH value was read after being constant for 30 s [38].
3. Result and Discussion
3.1. Isolation and Identification of Fungal Contaminants
The determination of microbial species on paper objects can effectively mitigate the risk of microbial diseases and develop antibacterial agents. Therefore, we carried out sampling, isolation, and identification for mold on paper objects. Based on colony morphology, eight fungi (Figure 3) were initially selected and isolated from the moldy papers. The rDNA-ITS sequence is presented in Supplementary Materials. According to the morphological characteristics and rDNA-ITS sequence analysis, strain A was Trichoderma harzianum [30], strain B was Penicillium oxalicum [25], strain C was Trichoderma sp. [30], strain D was Talaromyces wortmannii [29], strain E was Aspergillus flavus [26], strain F was Aspergillus fumigatus [24], strain G was Penicillium citrinum [28], and strain H was Aspergillus niger [27].

Figure 3.
Isolation and identification of related molds in the paper archives. Plate colony morphology (right-hand), spore hypha morphology (left-hand).
3.2. The Type of CH Microemulsion
The type of CH microemulsion was determined using the dyeing method, and identification results are shown in Figure 4. It can be seen that Sudan dye III remained on the surface of the microemulsion, while the methylene blue powder directly spread into the microemulsion under the action of gravity, forming a diffusion zone. This was because methylene blue is only soluble in water; the formation of the diffusion zone still continued, so we determined the CH microemulsion as the O/W type [39].

Figure 4.
The diffusion results of Sudan dye III (left) and methylene blue (right) in the CH microemulsion.
3.3. Globule Size and the Stability Analysis
A fundamental characterization was performed to determine particle size, zeta potential, and PDI in order to confirm the stability of the microemulsion and the homogeneity of the particle size distribution. CH microemulsion was transparent and monophasic, with a mean globule range of 15–43 nm, a zeta potential of 7.04 ± 0.2008 mV, and a uniform PDI of 0.206 ± 0.0045. Additionally, the lower the PDI, the better the size distribution of the globules, along with the stability of the formulation (Figure 5), indicating that the CH formulation had good dispersion stability [31,32,40].

Figure 5.
Particle size distribution of the CH formulation.
3.4. Transmission Electron Microscopy
In addition to measuring the average particle size of microemulsion droplets by photon correlation spectroscopy, based on the principle of dynamic light scattering (DLS), TEM could be used to obtain the morphological structure of the microemulsion in an intuitive way and to further verify whether the prepared microemulsion had a size of 10–100 nm [20]. The TEM was used to obtain information about the morphologies and distributions of the particles of the microemulsion systems. In the CH microemulsion, most of the particles were uniformly shaped (spherical) and had sizes in the range of 15–43 nm (Figure 6). Globule sizes measured via TEM analysis were in compliance with data measured using the Zetasizer (Figure 5).

Figure 6.
TEM image of the CH microemulsion.
3.5. Effect of Microemulsion Formulations on Mold
Paper cultural relics provided a suitable living environment for mold, resulting in environmental pollution, which poses a threat to the preservation of cultural relics and the health of workers [1]. In the present study, we selected Aspergillus niger and Aspergillus flavus as experimental strains to assess the bactericidal effect of three microemulsion preparations using the inhibition zone method. The results showed that a, b, and c had significant inhibitory effects on Aspergillus flavus and Aspergillus niger, and the effects of b and c were similar and superior to a, which verified that the combination of CTZ and HACC could inhibit Aspergillus flavus and Aspergillus niger (Figure 7A). Through screening the concentrations of CTZ and HACC and conducting an antibacterial performance study, a synergistic microemulsion formula was obtained (Table 1). The results showed that the treatment groups of C, H, and CH had bacteriostatic effects on the two kinds of molds, among which the combination of CTZ and HACC (CH) had the best effect, the effect of H and C was lower than that of CH, and the effect of C was the worst (Figure 7C). Therefore, it was verified that the combination of CTZ and HACC had a synergistic effect. In the follow-up archives protection experiment, CH will be used for archives mold prevention.

Figure 7.
The bactericidal effect of three sets of microemulsions on mold. (A) Inhibition zone of microemulsion formulations on 2 kinds of molds; (B) the process of the bacteriostasis experiment; (C) the survival rate of mold; (D) the synergy of CH.
3.6. Mechanical Property Test for Paper Samples after Treatment
In practices, antibacterial agents should not only have good antibacterial effects, it should also be ensured that they do not affect the durability and the mechanical properties of paper cultural relics. The strength indexes were determined to study the effects on paper mechanical properties by CH. Tensile index and folding endurance were investigated, and the results are shown in Figure 4. CH was selected, and four kinds of paper samples were processed. Compared with the blank group (untreated), the foldabilities of rice paper and manuscript paper did not decrease significantly, while the foldability of copy paper was improved. The tensile data of rice paper and copy paper did not decrease significantly, but the tensile data of manuscript paper increased significantly (Figure 8). In general, the folding resistances and tensility of the four kinds of paper samples treated with CH did not decrease significantly, indicating that CH had little effects on the physical properties of the four kinds of paper samples. The strength characteristic is an important factor to prolong the durability of paper cultural relics. This phenomenon indicates that CH as a mold-removal solution for paper cultural relics may have a durable application prospect.

Figure 8.
The comparison of control (untreated) paper and reinforced paper CH on the paper strength index, (A) folding endurance, and (B) tensile index.
3.7. Optical Properties
In addition to mechanical properties, whether CH has an impact on the appearance of paper cultural relics is also of great importance to the use of antibacterial agents. From the color measurement data (Table 3), it was clear that ΔE of the xuan paper was 0.49 after being treated with CH. It can be said that the ΔE was 1.13 for the manuscript paper treated with CH, followed by the A4 paper treated with CH, which recorded 0.28. It was clear that the color measurement indicated that CH microemulsion treatment had little effect on the appearance of the paper. Zervos and Moropoulou reported that the measurement of color change was used to assess the deterioration level of the paper. Results obtained for the CIE whiteness index is shown in Figure 9. Paper whiteness refers to the whiteness [37,38,39,40,41] of the paper, that is, the ability of the paper to fully reflect after being exposed to light. Figure 8 shows the whiteness values of rice paper, A4 paper, and manuscript paper before and after treatment. The whiteness values of the untreated xuan paper, A4 paper, and manuscript paper were 65.94%, 78.56%, and 76.07% respectively, and the whiteness values of the treated paper were 65.91%, 78.30%, and 75.46% respectively, showing a decrease in the whiteness values by 9.73 and 17.76%, respectively. Therefore, the whiteness values of the three processed papers and the three untreated papers were not significantly different. The ability of the paper to reflect color light was almost unchanged, and the visual effect did not change. In summary, in the case of optical properties, there were no significant changes in all coated papers in comparison with the treatment.

Table 3.
Color measurement of paper treated with CH and untreated.

Figure 9.
The CIE indexes of the different treated papers.
3.8. Measurement of pH Value
It is known that acidification plays an adverse role in paper stability [38], and therefore, pH was determined. The data in Table 4 revealed that the pH of the xuan paper was 6.7 before treatment and 5.9 after treatment with CH. The pH value of the untreated manuscript paper was 7.96, and the pH after being treated with CH was 7.78. The results displayed that the pH of the control sample of A4 paper was 8.26, and the pH of A4 paper treated with CH was 5.6 [38].

Table 4.
The pH of papers before and after treatment with microemulsion.
4. Conclusions
In this paper, the O/W microemulsion system containing CTZ and HACC was successfully prepared using a simple titration method. Meanwhile, the size range of the prepared CH microemulsion was 15–43 nm, the polydispersity index (PDI) was 0.206 ± 0.0045, and the zeta potential was 7.04 ± 0.2008 mV. The combination of transmission electron microscopy showed that the prepared microemulsion was uniform and stable. The synergistic effect of CTZ and HACC was verified to enhance the antifungal effect. The mechanical properties, optical properties, and pH values of the papers treated with CH were determined. It was proved that CH had no effects on the mechanical properties and appearance of the paper and would not cause acidification effects on the paper. In conclusion, CH has a lasting application prospect as a mildew-removal solution for paper cultural relics.
Supplementary Materials
The following supporting information can be downloaded at: https://www.mdpi.com/article/10.3390/coatings13040745/s1.
Author Contributions
Conceptualization, N.L.; resources, N.L.; methodology, D.C.; investigation, X.C. (Xianlin Chen); formal analysis, H.X.; data curation, X.C. (Xiaolian Chao); writing—original draft preparation, N.L.; visualization, P.F.; writing—review and editing, Y.L. (Yujia Luo) and B.M.; supervision, project administration, and funding acquisition, Y.L. (Yuhu Li). All authors have read and agreed to the published version of the manuscript.
Funding
The authors gratefully acknowledge the financial support by the National Natural Science Foundation of China (No. 22102094), the Fundamental Research Funds for the Central Universities (GK 202205024), and the Key Research and Development Program of Shaanxi Province, China (No. 2023-YBGY-413), as well as the Industry and Education Cooperative Education Program of the Ministry of Education of China (No. 220604755080141).
Institutional Review Board Statement
Not applicable.
Informed Consent Statement
Not applicable.
Data Availability Statement
The datasets used and/or analysis results obtained in the current study are available from the corresponding author upon request.
Acknowledgments
The authors thank the Shaanxi Provincial Archives of China for their support and help in this project.
Conflicts of Interest
The authors declare that they have no conflict of interest related to this work. We declare that we do not have any commercial or associative interests that represent conflict of interest in connection with the work submitted.
References
- Mai, B.; Liu, N.; Liu, X.; Teri, G.; Liu, P.; Wang, J.; Li, Y.; Cao, J. Mould prevention of archive packaging based microenvironment intervention and regulation. J. Cult. Herit. 2022, 57, 16–25. [Google Scholar] [CrossRef]
- Xu, J.; Zhang, T.; Jiang, Y.; Chen, Q.; Yang, D.; Qiu, F.; Yu, Z. Synthesis of microcrystalline cellulose/TiO2/fluorine/styrene-acrylate coatings and the application for simulated paper cultural relic protection. Cellulose 2020, 27, 6549–6562. [Google Scholar] [CrossRef]
- Duan, Y.; Chen, R.; Zhang, R.; Jiang, W.; Chen, X.; Yin, C.; Mao, Z. Isolation, Identification, and Antibacterial Mechanisms of Bacillus amyloliquefaciens QSB-6 and Its Effect on Plant Roots. Front. Microbiol. 2021, 12, 746799. [Google Scholar] [CrossRef] [PubMed]
- Chen, Z.; Zou, J.; Chen, B.; Du, L.; Wang, M. Protecting books from mould damage by decreasing paper bioreceptivity to fungal attack using decoloured cell-free supernatant of Lysobacter enzymogenes C3. J. Appl. Microbiol. 2019, 126, 1772–1784. [Google Scholar] [CrossRef]
- Lech, T. Evaluation of a Parchment Document, the 13th Century Incorporation Charter for the City of Krakow, Poland, for Microbial Hazards. Appl. Environ. Microbiol. 2016, 82, 2620–2631. [Google Scholar] [CrossRef]
- Sawoszczuk, T.; Syguła-Cholewińska, J.; del Hoyo-Meléndez, J.M. Application of HS-SPME-GC-MS method for the detection of active moulds on historical parchment. Anal. Bioanal. Chem. 2017, 409, 2297–2307. [Google Scholar] [CrossRef]
- Sterflinger, K. Fungi: Their role in deterioration of cultural heritage. Fungal Biol. Rev. 2010, 24, 47–55. [Google Scholar] [CrossRef]
- Lugauskas, A.; Krikŝtaponis, A. Microscopic Fungi Found in the Libraries of Vilnius and Factors Affecting their Development. Indoor Built Environ. 2004, 13, 169–182. [Google Scholar] [CrossRef]
- Lavin, P.; de Saravia, S.G.; Guiamet, P. Scopulariopsis sp. and Fusarium sp. in the Documentary Heritage: Evaluation of Their Biodeterioration Ability and Antifungal Effect of Two Essential Oils. Microb. Ecol. 2016, 71, 628–633. [Google Scholar] [CrossRef]
- Hashem, F.M.; Shaker, D.S.; Ghorab, M.K.; Nasr, M.; Ismail, A. Formulation, characterization, and clinical evaluation of microemulsion containing clotrimazole for topical delivery. AAPS PharmSciTech 2011, 12, 879–886. [Google Scholar] [CrossRef]
- Ritter, W.; Patzschke, K.; Krause, U.; Stettendorf, S. Pharmacokinetic fundamentals of vaginal treatment with clotrimazole. Chemotherapy 1982, 28 (Suppl. 1), 37–42. [Google Scholar] [CrossRef] [PubMed]
- Pedersen, M.; Bjerregaard, S.; Jacobsen, J.; Sørensen, A.M. A genuine clotrimazole γ-cyclodextrin inclusion complex-isolation, antimycotic activity, toxicity and an unusual dissolution rate. Int. J. Pharm. 1998, 176, 121–131. [Google Scholar] [CrossRef]
- Osman, S.F.; Fett, W.F. Structure of the acidic exopolysaccharide of Pseudomonas marginalis strain ATCC 10844. Carbohydr. Res. 1993, 242, 271–275. [Google Scholar] [CrossRef] [PubMed]
- Jia, Z.; Shen, D.; Xu, W. Synthesis and antibacterial activities of quaternary ammonium salt of chitosan. Carbohydr. Res. 2001, 333, 1–6. [Google Scholar] [CrossRef] [PubMed]
- Zhang, W.; Dai, X.; Zhou, J.; Zhu, G. Antibacterial Bombyx Mori silk fabric modified with reactive chitosan quaternary ammonium salt and its laundering durability. Fibers Polym. 2017, 18, 290–295. [Google Scholar] [CrossRef]
- Zhang, J.; Tan, W.; Li, Q.; Liu, X.; Guo, Z. Preparation of Cross-linked Chitosan Quaternary Ammonium Salt Hydrogel Films Loading Drug of Gentamicin Sulfate for Antibacterial Wound Dressing. Mar. Drugs 2021, 19, 479. [Google Scholar] [CrossRef]
- Chen, M.; Hu, Y.; Zhou, J.; Xie, Y.; Wu, H.; Yuan, T.; Yang, Z. Facile fabrication of tea tree oil-loaded antibacterial microcapsules by complex coacervation of sodium alginate/quaternary ammonium salt of chitosan. RSC Adv. 2016, 6, 13032–13039. [Google Scholar] [CrossRef]
- Zhang, W.; Zhou, J.J.; Dai, X.L. Preparation and characterization of reactive chitosan quaternary ammonium salt and its application in antibacterial finishing of cotton fabric. Text. Res. J. 2016, 87, 759–765. [Google Scholar] [CrossRef]
- Borhade, V.; Pathak, S.; Sharma, S.; Patravale, V. Clotrimazole nanoemulsion for malaria chemotherapy. Part I: Preformulation studies, formulation design and physicochemical evaluation. Int. J. Pharm. 2012, 431, 138–148. [Google Scholar] [CrossRef]
- Kumari, B.; Kesavan, K. Effect of chitosan coating on microemulsion for effective dermal clotrimazole delivery. Pharm. Dev. Technol. 2017, 22, 617–626. [Google Scholar] [CrossRef]
- Zhang, J.; Michniak-Kohn, B.B. Investigation of microemulsion and microemulsion gel formulations for dermal delivery of clotrimazole. Int. J. Pharm. 2018, 536, 345–352. [Google Scholar] [CrossRef] [PubMed]
- Grimling, B.; Karolewicz, B.; Nawrot, U.; Wlodarczyk, K.; Gorniak, A. Physicochemical and Antifungal Properties of Clotrimazole in Combination with High-Molecular Weight Chitosan as a Multifunctional Excipient. Mar. Drugs 2020, 18, 591. [Google Scholar] [CrossRef]
- Alam, M.A.; Al-Janoobi, F.I.; Alzahrani, K.A.; Al-Agamy, M.H.; Abdelgalil, A.A.; Al-Mohizea, A.M. In-vitro efficacies of topical microemulsions of clotrimazole and ketoconazole; and in-vivo performance of clotrimazole microemulsion. J. Drug Deliv. Sci. Technol. 2017, 39, 408–416. [Google Scholar] [CrossRef]
- Wassano, N.S.; Goldman, G.H.; Damasio, A. Aspergillus fumigatus. Trends Microbiol. 2020, 28, 594–595. [Google Scholar] [CrossRef]
- Xu, Q.; Jiang, X.; Tong, J.; Wu, H.; Luo, Y.; Shi, J. Penicillium oxalicum SL2 as a sustainable option to mitigate the accumulation of Pb in rice (Oryza sativa L.). Sci. Total Environ. 2022, 823, 153769. [Google Scholar] [CrossRef] [PubMed]
- Amaike, S.; Keller, N.P. Aspergillus flavus. Annu. Rev. Phytopathol. 2011, 49, 107–133. [Google Scholar] [CrossRef]
- Schuster, E.; Dunn-Coleman, N.; Frisvad, J.; van Dijck, P. On the safety of Aspergillus niger—A review. Appl. Microbiol. Biotechnol. 2002, 59, 426–435. [Google Scholar] [CrossRef] [PubMed]
- Khan, S.A.; Hamayun, M.; Yoon, H.; Kim, H.Y.; Suh, S.J.; Hwang, S.K.; Kim, J.M.; Lee, I.J.; Choo, Y.S.; Yoon, U.H.; et al. Plant growth promotion and Penicillium citrinum. BMC Microbiol. 2008, 8, 231. [Google Scholar] [CrossRef] [PubMed]
- Peterson, S.W.; Jurjević, Ž. New species of Talaromyces isolated from maize, indoor air, and other substrates. Mycologia 2017, 109, 537–556. [Google Scholar] [CrossRef]
- Asis, A.; Shahriar, S.A.; Naher, L.; Saallah, S.; Fatihah, H.N.N.; Kumar, V.; Siddiquee, S. Identification patterns of Trichoderma strains using morphological characteristics, phylogenetic analyses and lignocellulolytic activities. Mol. Biol. Rep. 2021, 48, 3285–3301. [Google Scholar] [CrossRef]
- Gaba, B.; Khan, T.; Haider, M.F.; Alam, T.; Baboota, S.; Parvez, S.; Ali, J. Vitamin E Loaded Naringenin Nanoemulsion via Intranasal Delivery for the Management of Oxidative Stress in a 6-OHDA Parkinson’s Disease Model. Biomed. Res. Int. 2019, 2019, 2382563. [Google Scholar] [CrossRef] [PubMed]
- Srivastava, M.; Kohli, K.; Ali, M. Formulation development of novel in situ nanoemulgel (NEG) of ketoprofen for the treatment of periodontitis. Drug Deliv. 2016, 23, 154–166. [Google Scholar] [CrossRef] [PubMed]
- Carlsson, L.A.; Lindstrom, T. A shear-lag approach to the tensile strength of paper. Compos. Sci. Technol. 2005, 65, 183–189. [Google Scholar] [CrossRef]
- Kamel, S.; El-Sakhawy, M.; Nada, A.M.A. Mechanical properties of the paper sheets treated with different polymers. Thermochim. Acta 2004, 421, 81–85. [Google Scholar] [CrossRef]
- Wu, X.; Mou, H.; Fan, H.; Yin, J.; Liu, Y.; Liu, J. Improving the flexibility and durability of aged paper with bacterial cellulose. Mater. Today Commun. 2022, 32, 103827. [Google Scholar] [CrossRef]
- Fu, P.; Teri, G.-L.; Chao, X.-L.; Li, J.; Li, Y.-H.; Yang, H. Modified Graphene-FEVE Composite Coatings: Application in the Repair of Ancient Architectural Color Paintings. Coatings 2020, 10, 1162. [Google Scholar] [CrossRef]
- Milanovic, J.; Lazic, T.; Zivkovic, I.; Vuksanovic, M.; Milosevic, M.; Kostic, M. The Effect of Nanofibrillated Tempo-oxidized Cotton Linters on the Strength and Optical Properties of Paper. J. Nat. Fibers 2020, 19, 3993–4006. [Google Scholar] [CrossRef]
- Vajová, I.; Vizárová, K.; Tiňo, R.; Krivoňáková, N.A.; Takáč, Z.; Katuščák, S. Determination of pH distribution through pH-related properties in deacidified model paper. Eur. Phys. J. Plus 2021, 136, 578. [Google Scholar] [CrossRef]
- McClements, D.J. Nanoemulsions versus microemulsions: Terminology, differences, and similarities. Soft Matter 2012, 8, 1719–1729. [Google Scholar] [CrossRef]
- Garti, N.; Spernath, A.; Aserin, A.; Lutz, R. Nano-sized self-assemblies of nonionic surfactants as solubilization reservoirs and microreactors for food systems. Soft Matter 2005, 1, 206–218. [Google Scholar] [CrossRef]
- Adel, A.M.; Ahmed, N.M.; Diab, M.A.; Selim, M.M. The influence of TiO2/CC core/shell pigments on the properties of paper sheets. Powder Technol. 2016, 291, 437–447. [Google Scholar] [CrossRef]
Disclaimer/Publisher’s Note: The statements, opinions and data contained in all publications are solely those of the individual author(s) and contributor(s) and not of MDPI and/or the editor(s). MDPI and/or the editor(s) disclaim responsibility for any injury to people or property resulting from any ideas, methods, instructions or products referred to in the content. |
© 2023 by the authors. Licensee MDPI, Basel, Switzerland. This article is an open access article distributed under the terms and conditions of the Creative Commons Attribution (CC BY) license (https://creativecommons.org/licenses/by/4.0/).